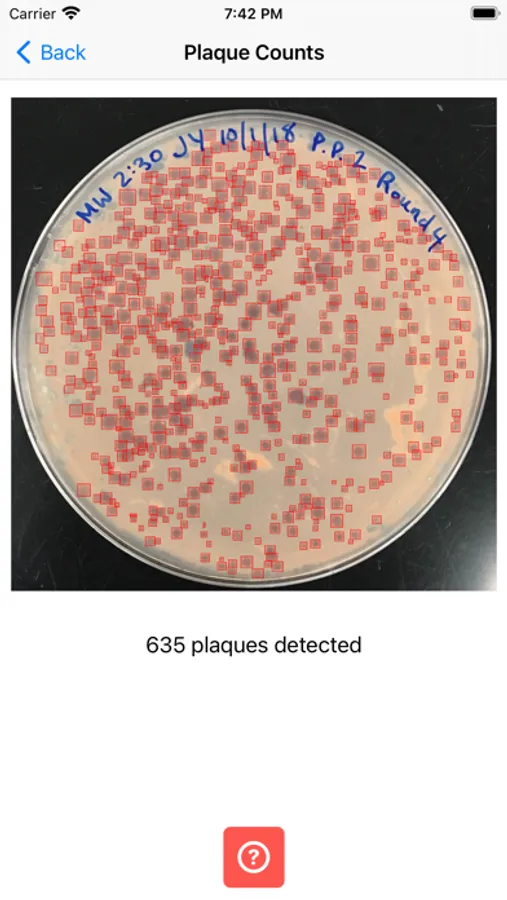

AppRecs review analysis
AppRecs rating 3.1. Trustworthiness 0 out of 100. Review manipulation risk 0 out of 100. Based on a review sample analyzed.
★★★☆☆
3.1
AppRecs Rating
Ratings breakdown
5 star
29%
4 star
14%
3 star
29%
2 star
0%
1 star
29%
About OnePetri
Harness the power of AI and accelerate common microbiological petri dish assays with OnePetri!
Tired of manually counting plaques on petri dishes? Count plaques in near real-time with OnePetri, an automated plaque counting iOS app!
OnePetri currently supports bacteriophage plaque-based assays, with support for bacterial CFU counts coming in a future release!
=== About OnePetri ===
OnePetri uses machine learning models & computer vision to automatically detect petri dishes and plaques, count plaques, and perform common assay calculations with these values (plaque/titration assay).
Note that as of now, OnePetri only works with circular petri dishes; however, other shapes (square & rectangle) may be added if sufficient training images can be obtained. Additionally, the models used in the app require one plate per dilution, and as such, spot assays are not currently supported.
All image processing & detection is done locally on-device, with no need for an internet connection once the app has been installed. As such, OnePetri does not collect, store, or transmit any user data or images. Updates are likely to be released regularly, so regular access to the internet is strongly recommended.
=== Plaque count accuracy & validation ===
There are no restrictions on how OnePetri is used; however, the models included in the app may occasionally miscount plaques (too many, or too few) and this could affect downstream experiments and calculations. As such, all counts done by the app should always be validated by manual counting or another established "gold standard", especially in cases where it is critical to know precise values (ie. phage titration for phage therapy). The model accuracy will improve with each release thanks to additional training data provided by the community.
OnePetri is completely open source, with the initial training dataset and app source code publicly available! For more information on how to contribute to the app's codebase, please visit the OnePetri website (https://onepetri.ai).
Tired of manually counting plaques on petri dishes? Count plaques in near real-time with OnePetri, an automated plaque counting iOS app!
OnePetri currently supports bacteriophage plaque-based assays, with support for bacterial CFU counts coming in a future release!
=== About OnePetri ===
OnePetri uses machine learning models & computer vision to automatically detect petri dishes and plaques, count plaques, and perform common assay calculations with these values (plaque/titration assay).
Note that as of now, OnePetri only works with circular petri dishes; however, other shapes (square & rectangle) may be added if sufficient training images can be obtained. Additionally, the models used in the app require one plate per dilution, and as such, spot assays are not currently supported.
All image processing & detection is done locally on-device, with no need for an internet connection once the app has been installed. As such, OnePetri does not collect, store, or transmit any user data or images. Updates are likely to be released regularly, so regular access to the internet is strongly recommended.
=== Plaque count accuracy & validation ===
There are no restrictions on how OnePetri is used; however, the models included in the app may occasionally miscount plaques (too many, or too few) and this could affect downstream experiments and calculations. As such, all counts done by the app should always be validated by manual counting or another established "gold standard", especially in cases where it is critical to know precise values (ie. phage titration for phage therapy). The model accuracy will improve with each release thanks to additional training data provided by the community.
OnePetri is completely open source, with the initial training dataset and app source code publicly available! For more information on how to contribute to the app's codebase, please visit the OnePetri website (https://onepetri.ai).
OnePetri Screenshots
Tap to Rate: